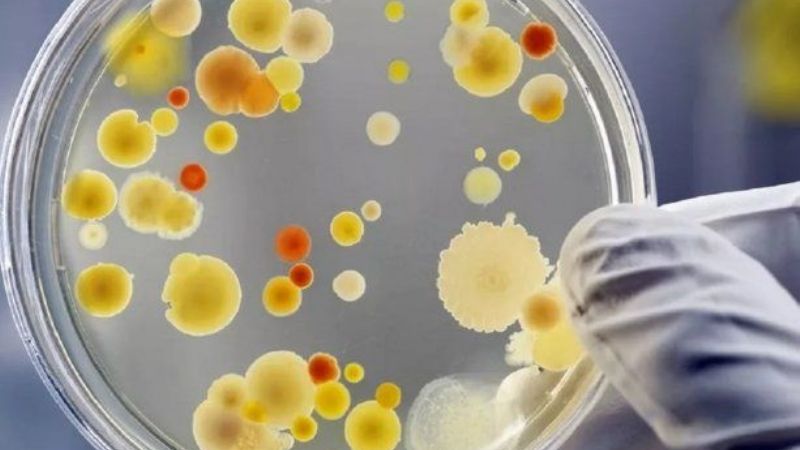
Alerta por brote de casos de Súper Hongo en Brasil

Brasil declaró este miércoles el estado de "brote local" al detectar en su territorio un tercer caso positivo del Súper Hongo, como se conoce al Candida auris.
Según precisó la Agencia Nacional de Vigilancia Sanitaria (Anvisa), el tercer contagiado es un hombre internado en Recife. "Se tomaron acciones para contener la propagación del organismo en el hospital y todavía hay otro caso sospechoso, que está bajo investigación", añadieron.
El organismo remarcó que "aunque por el momento solo hay tres casos confirmados y otro en análisis en Brasil, se puede considerar que hay un brote de Candida auris en el país".
Desde la Agencia detallaron que la "definición epidemiológica" de un brote "abarca no solo una gran cantidad de casos de enfermedades contagiosas o relacionadas con la salud, sino también la aparición de un nuevo microorganismo en la epidemiología de un país o incluso de un servicio de salud, incluso si es solo un caso".
Qué es el Súper Hongo
De acuerdo con los científicos, el virus del Súper Hongo implica serios riesgos para personas con sistemas inmunológicos comprometidos o hospitalizados en unidades de cuidados intensivos que precisan catéteres y sondas vasculares.
Provoca infecciones sanguíneas graves y se propaga entre pacientes internados en hospitales y hogares de ancianos; mientras que el contagio se da por contacto entre personas y por contacto prolongado con superficies o dispositivos médicos contaminados por la cepa.
Entre sus síntomas figuran fiebre y escalofríos, y se estima que uno de cada tres contagiados fallece por una infección masiva al mes de recibir el diagnóstico. Si ninguno de los síntomas mejoran después de tratarse con antibióticos, se puede sospechar de una infección bacteriana.
El Súper Hongo fue detectado por primera vez en 2009, cuando se encontró en el canal auditivo de un paciente en Corea del Sur. A partir de esa fecha se hallaron casos en más de treinta países, como Estados Unidos, Inglaterra, Venezuela, Colombia, Israel, Pakistán, Kenia, Kuwait y España, aparte de Brasil.
El Súper Hongo podría ser la próxima pandemia
Los Centros para el Control y la Prevención de Enfermedades de los Estados Unidos (CDC, por sus siglas en inglés), manifestaron que "la amenaza para la salud mundial es tan grave que puede considerarse que el Súper Hongo es la causa de la próxima pandemia".
El Candida auris crece como levadura y se ha descartado el uso de desinfectantes para contrarrestarlo, motivo por el cual se lo considera como el "patógeno casi perfecto".